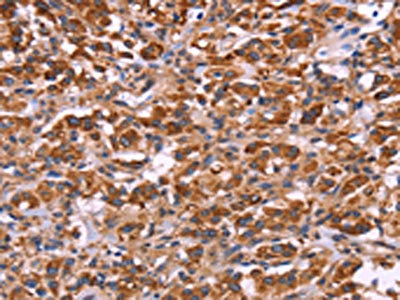

MMP14 Antibody
-
中文名稱:MMP14兔多克隆抗體
-
貨號:CSB-PA553918
-
規格:¥1100
-
圖片:
-
The image on the left is immunohistochemistry of paraffin-embedded Human gastic cancer tissue using CSB-PA553918(MMP14 Antibody) at dilution 1/40, on the right is treated with fusion protein. (Original magnification: ×200)
-
The image on the left is immunohistochemistry of paraffin-embedded Human thyroid cancer tissue using CSB-PA553918(MMP14 Antibody) at dilution 1/40, on the right is treated with fusion protein. (Original magnification: ×200)
-
-
其他:
產品詳情
-
Uniprot No.:
-
基因名:
-
別名:Matrix metallopeptidase 14 (membrane inserted) antibody; Matrix metalloproteinase 14 antibody; Matrix metalloproteinase-14 antibody; Membrane type 1 matrix metalloproteinase antibody; Membrane type 1 metalloprotease antibody; Membrane type matrix metalloproteinase 1 antibody; Membrane-type matrix metalloproteinase 1 antibody; Membrane-type-1 matrix metalloproteinase antibody; MMP 14 antibody; MMP X1 antibody; MMP-14 antibody; MMP-X1 antibody; Mmp14 antibody; MMP14_HUMAN antibody; MMPX1 antibody; MT MMP 1 antibody; MT-MMP 1 antibody; MT1 MMP antibody; MT1-MMP antibody; MT1MMP antibody; MTMMP 1 antibody; MTMMP1 antibody
-
宿主:Rabbit
-
反應種屬:Human,Mouse,Rat
-
免疫原:Fusion protein of Human MMP14
-
免疫原種屬:Homo sapiens (Human)
-
標記方式:Non-conjugated
-
抗體亞型:IgG
-
純化方式:Antigen affinity purification
-
濃度:It differs from different batches. Please contact us to confirm it.
-
保存緩沖液:-20°C, pH7.4 PBS, 0.05% NaN3, 40% Glycerol
-
產品提供形式:Liquid
-
應用范圍:ELISA,IHC
-
推薦稀釋比:
Application Recommended Dilution ELISA 1:2000-1:5000 IHC 1:50-1:200 -
Protocols:
-
儲存條件:Upon receipt, store at -20°C or -80°C. Avoid repeated freeze.
-
貨期:Basically, we can dispatch the products out in 1-3 working days after receiving your orders. Delivery time maybe differs from different purchasing way or location, please kindly consult your local distributors for specific delivery time.
-
用途:For Research Use Only. Not for use in diagnostic or therapeutic procedures.
相關產品
靶點詳情
-
功能:Endopeptidase that degrades various components of the extracellular matrix such as collagen. Activates progelatinase A. Essential for pericellular collagenolysis and modeling of skeletal and extraskeletal connective tissues during development. May be involved in actin cytoskeleton reorganization by cleaving PTK7. Acts as a positive regulator of cell growth and migration via activation of MMP15. Involved in the formation of the fibrovascular tissues in association with pro-MMP2. Cleaves ADGRB1 to release vasculostatin-40 which inhibits angiogenesis.
-
基因功能參考文獻:
- Melatonin disturbs SUMOylation-mediated crosstalk between c-Myc and nestin via MT1 activation and promotes the sensitivity of paclitaxel in brain cancer stem cells PMID: 29654697
- The results suggest that MMP-14 is involved in proliferative diabetic retinopathy angiogenesis. PMID: 29853773
- MMP14 down-regulated the expression of TNF-alpha to inhibit extracellular matrix and MMP14 down-regulation was found to impair the proliferation and invasion ability of cervical cancer cells. PMID: 30355924
- High expression of mmp14 is associated with preeclampsia. PMID: 29363569
- Study suggest that the downregulation of miR1505p and the overexpression of MMP14 may be deeply involved in the pathogenesis of lung squamous cell carcinoma. PMID: 29286099
- the expression of three cytokines for the pathogenesis of osteoarthritis (OA). which include IL-1beta, MMP14 and GRP78 was decreased by the various concentrations of icariin. These preliminary results imply that icariin might be an effective compound for the treatment of OA disease. PMID: 29292760
- Overexpression of MMP-14 in familial amyloidotic polyneuropathy might be associated with the inflammatory process and can also contribute to further remodeling of the ECM. PMID: 28993312
- MMP14 rs1042703 was associated with nominally shorter time to progression in malignant mesothelioma patients. PMID: 29138529
- analysis of MT1-MMP structure and proteolytic activity PMID: 27405411
- In squamous cell carcinoma of the cervix (SCCC), higher levels of MMP-14 expression were established in tumor cells, as evidenced by IHC (+3) and RT-PCR.Furin activity in the tumor was much higher than that in normal tissues. The expression of TIMP-2 mRNA was sufficiently obvious in both the tumor and normal tissues to the bottom of the uterine cavity. PMID: 29265076
- MMP-14 is regulated by a cascade of IL-6 and p53, demonstrating that the tumor microenvironment directly stimulates molecular changes in cancer cells to drive an invasive phenotype PMID: 27531896
- MMP-14 levels decrease in lungs from endotoxemic mice and serum from septic patients. * Mmp14 (-/-) mice show increased lung injury and mortality following endotoxemia. * Absence of Mmp14 decreases activated MMP-2 and increases S100A9 levels in lung tissue. * MMP-14 ameliorates inflammation by promoting S100A9 cleavage by activated MMP-2. PMID: 28120021
- miR-337-3p directly binds to the MMP-14 promoter to repress MZF1-facilitatd MMP-14 expression, thus suppressing the progression of gastric cancer PMID: 27259238
- CCN3 (Nov) and CCN5 (WISP2) are novel substrates of MMP14. PMID: 27471094
- The current data support MT1-MMP as an additional ILK substrate and show that modulation of ILK expression and activity inhibit MT1-MMP-related pro-metastatic behaviors of ovarian cancer cells. PMID: 26959113
- Endoplasmic reticulum (ER) glycosylation of MMP14 is required for ECM degradation and tumor growth. PMID: 29136507
- Authors demonstrate that CAIX associates with MMP14 through potential phosphorylation residues within its intracellular domain, and that CAIX enhances MMP14-mediated collagen degradation by directly contributing hydrogen ions required for MMP14 catalytic activity. PMID: 28692057
- developed a GNP-based, near-infrared fluorescent contrast agent that is highly specific for MMP-14 detection in breast tumor cell lines. PMID: 27526171
- ERO1alpha plays a crucial role in HSC proliferation via posttranslational modification of collagen and MT1-MMP PMID: 28774960
- MT1-MMP-expressing cells induced co-cultured non-MT1-MMP-expressing cells. PMID: 26881932
- The mechanism of transition from nondifferentiated to differentiated states in HepaRG cells was studied by proteomics. Two key factors (MMP-14 and OCLN) were validated by qRT-PCR and Western blot. Blockade of MMP-14 further demonstrated its important function during tumor cell migration. PMID: 27790907
- Data suggest that phosphorylation of Thr567 in cytoplasmic tail of MT1-MMP (MMP14) influences behavior of both individual ovarian cancer cells and multicellular aggregates; tumor cells expressing MT1-MMP-T567E phosphomimetic mutant exhibit enhanced cell migration and enhanced cell adhesion to peritoneum and other biological surfaces. PMID: 28655772
- MMP-14 Is a novel substrate for matriptase, which regulates the levels of MMP-14 on the cell surface. High levels of matriptase in alpha-1 antitrypsin deficiency may contribute to increased extracellular matrix degradation by alveolar macrophages both directly and through MMP-14 activation. PMID: 28362108
- High expression of MMP14 and CDK7 was independent prognostic factors for overall survival in patients with gastric cancer. PMID: 27562173
- only collagen-IV elicits the formation of proteolytically active podosomes through a mechanism involving increased Src phosphorylation, p190RhoGAP-B (also known as ARHGAP5) relocalisation and MT1-MMP (also known as MMP14) cell surface exposure at podosome sites. PMID: 27231093
- This study demonstrates that excessive ECM degradation mediated by high levels of MT1-MMP is not associated with cell migration and tumourigenesis, while low levels of MT1-MMP promote invasion and vascularization in vivo. PMID: 27756325
- DDR2 mediates collagen-induced activation of MT1-MMP in human fibroblasts PMID: 28270508
- results suggest that the cytoplasmic domain regulates MT1-MMP function in a manner required for cell survival, but is dispensable for cell migration PMID: 27889376
- MMP14 plays an important mechanistic role in NSCLC progression, by supporting cancer invasiveness, promoting collagen degradation, and releasing HB-EGF, which accelerates lung tumor progression. PMID: 28013056
- We conclude that ADAM12 and MMP-14 are associated with cavernous sinus invasion in pituitary adenomas, which qualifies these proteins in diagnosis and therapy. PMID: 27144841
- The results suggest a regulatory role of miRNA-410 in modulating levels of MMP-14 in endometrial cancer PMID: 26842619
- Studies demonstrate that the interaction Bst-2 and MT1-MMP, actually happens and the cytoplasmic tails, both the N-terminal domain of Bst-2 and the C-terminal domain of MT1-MMP, play crucial roles in the interaction. The interaction between Bst-2 and MT1-MMP is important in MT1-MMP regulating the tetherin activity of Bst-2 and also in Bst-2 regulating the activity of the MT1-MP/proMMP2/MMP2 pathway. PMID: 27240342
- The subgroup of patients with double expression of MMP-14 and CD44 had a poor prognosis despite complete debulking. Serous subtype in advanced-stage patients and CD44 expression were found to be correlated with vimentin expression, and CD44 expression was found to be significantly correlated with complete debulking PMID: 27590006
- Akt level was reduced in preeclamptic placentas relative to preterm control. Inhibition of PI3K/Akt resulted in significantly elevated soluble endoglin release from endothelial cells, had no effect on MMP14 mRNA expression but resulted in significantly reduced TIMP3. In contrast inhibiting PI3K/Akt in placental explants or primary trophoblast did not change soluble endoglin release. PMID: 27155335
- possible involvement of membrane-type 1 matrix metalloproteinase processing of erythropoietin-producing hepatocellular receptor-2in invasiveness of cutaneous cutaneous squamous cell carcinoma PMID: 27056569
- Findings suggest that regulation of cellular trafficking and microtubule-mediated localization of MT1-MMP by mDia1 is likely important in breast cancer invasion through the expression of cancer stem cell genes. PMID: 26893363
- The results suggest that MT1-MMP promotes esophageal squamous cell carcinoma invasion and metastasis. PMID: 26916665
- Report design of PEGylated peptide probes conjugated with (18)F-labeled BODIPY to be used as a hybrid PET/optical imaging agent and for non-invasive monitoring of MT1-MMP activity in cancers. PMID: 26578437
- Downregulation of miR-193a-3p promoted loss of type II collagen by directly targeting MMP14 in IDD. miR-193a-3p inhibited IDD in vitro and in vivo. miR-193a-3p may be a promising candidate for prevention of degenerative disc disease. PMID: 26620678
- These results suggest that KLF6 regulates MMP14 transcription and is a critical player of the gene expression network triggered during endothelial repair. PMID: 26850053
- In summary, clinical and cell-based experiments suggested that physical interaction between MT1-MMP and ADI1 led to suppression of hepatitis C virus infection. This inhibitory effect could be reversed by ADI1 overexpression. PMID: 26537061
- Matrix metalloproteinase 14 was highly expressed in uterine leiomyoma and correlated with myostatin and activin A mRNA expression. Moreover, MMP14 and myostatin mRNA expression correlated significantly and directly with the intensity of dysmenorrhea. PMID: 26138721
- Hic-5 appears to enhance complex formation between MT1-MMP and FAK in activated endothelial cells, which likely coordinates matrix proteolysis and cell motility. PMID: 26769900
- Increased MMP14 expression is associated with malignant phenotype of cervical cancer. PMID: 26825836
- Silencing KIF1B inhibited expression of membranal MT1-MMP in glioma cells; however, the amount of MT1-MMP in the whole cell lysate was not affected. PMID: 26576027
- Independent prognostic value of MMP-14 expression in ovarian cancer is limited to a role in PFS for stromal MMP-14. PMID: 27038607
- Data indicate that miR-337-3p directly binds the MMP-14 promoter to repress its transcription, thus suppressing the progression of NB. PMID: 26084291
- Results identify the tumor suppressor SPRY4 as a novel molecular effector of MT1-MMP affecting melanoma cell motility. PMID: 26392417
- Pressure and Temperature Effects on the Activity and Structure of the Catalytic Domain of Human MT1-MMP PMID: 26636948
- MiR-22 downregulation promotes GC invasion and metastasis by upregulating MMP14 and Snail, and then inducing ECM remodeling and EMT. PMID: 26610210
顯示更多
收起更多
-
相關疾病:Winchester syndrome (WNCHRS)
-
亞細胞定位:Membrane; Single-pass type I membrane protein. Melanosome. Cytoplasm. Note=Identified by mass spectrometry in melanosome fractions from stage I to stage IV. Forms a complex with BST2 and localizes to the cytoplasm.
-
蛋白家族:Peptidase M10A family
-
組織特異性:Expressed in stromal cells of colon, breast, and head and neck. Expressed in lung tumors.
-
數據庫鏈接:
Most popular with customers
-
-
YWHAB Recombinant Monoclonal Antibody
Applications: ELISA, WB, IHC, IF, FC
Species Reactivity: Human, Mouse, Rat
-
Phospho-YAP1 (S127) Recombinant Monoclonal Antibody
Applications: ELISA, WB, IHC
Species Reactivity: Human
-
-
-
-
-